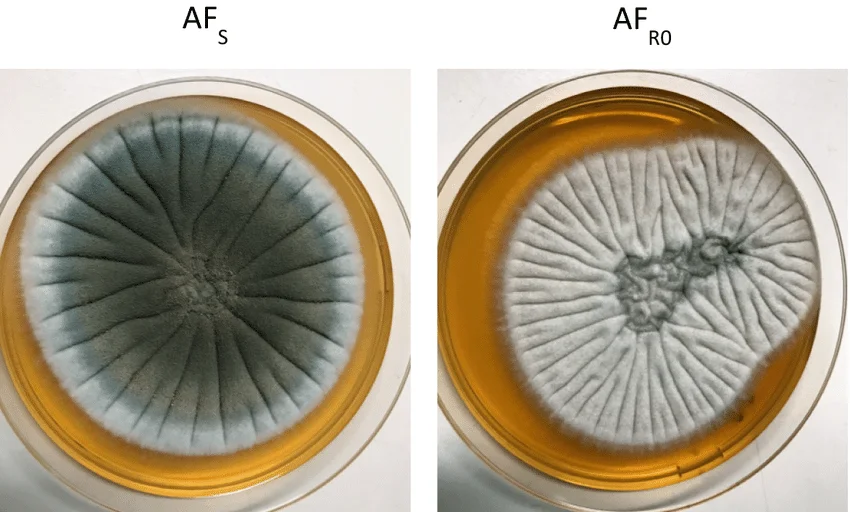
محیط کشت yepd

فهرست مطالب
نمایش
- مخمرها، یوکاریوتهای (Eukaryote) تک سلولی هستند و در ژنتیک مولکولی به طور گسترده مورد مطالعه قرار گرفتهاند.
- آنها شیمیوارگانوتروف (Chemoorganotroph) هستند زیرا از ترکیبات آلی به عنوان منبع انرژی استفاده میکنند.
- آگار YEPD یا YPD برای نگهداری و تکثیر مخمرها از جمله ساکارومایسس سرویزیه ( cerevisiae) در روشهای مختلف میکروبیولوژی مولکولی استفاده میشود.
- YPD به عنوان یک محیط کامل برای رشد مخمر عمل میکند.
ترکیبات آگار YEPD
| مواد تشکیل دهنده | گرم در لیتر |
| پپتون | 20 |
| عصاره مخمر | 10 |
| دکستروز | 20 |
| آگار | 15 |
pH نهایی (در دمای 25 درجه سانتیگراد): 0.2 ± 6.5
اصول آگار YEPD
- YEPD از عصاره مخمر، پپتون و گلوکز یا دکستروز تشکیل شده است.
- مخمرها در محیط کشت مینیمالی (Minimal medium) که فقط حاوی دکستروز و نمک باشد به خوبی رشد میکنند.
- افزودن پروتئین و هیدرولیزهای عصاره سلولی مخمر باعث رشد سریعتر در طول مرحله رشد نمایی یا لگاریتمی میشود.
- عصاره مخمر ویتامینهای B کمپلکس را تامین میکند و حاوی تمام اسیدهای آمینه لازم برای رشد میباشد.
- پپتون به عنوان منبع نیتروژن، ویتامینها و مواد معدنی عمل میکند.
- دکستروز به عنوان منبع کربن عمل میکند.
- این محیط، رشد زیاد گونه وحشی و همچنین گونههای جهش یافته انواع مخمرهای جوانهدار را تقویت میکند.
تهیه آگار YEPD
- 65 گرم از پودر را در 1 لیتر آب تصفیه شده بریزید.
- آن را کاملا مخلوط کنید.
- محیط آگار را با هم زدن مکرر حرارت داده و به مدت 1 دقیقه بجوشانید تا پودر کاملا حل شود.
- محیط آگار و براث (Broth) را در دمای 121 درجه سانتیگراد به مدت 15 دقیقه اتوکلاو کنید.
- محیط را تا دمای 45 تا 50 درجه سانتیگراد خنک کنید.
- آن را به طور مساوی در پلیتهای پتری (Petri plate) بریزید.
تفسیر نتیجه در آگار YEPD
| ارگانیسمها | رشد |
| Kluyveromyces lactis | رشد بسیار زیاد |
| Saccharomyces cerevisiae | رشد بسیار زیاد؛ کلنیهای صاف، مرطوب و درخشان |
| Candida albicans | رشد بسیار زیاد |
موارد استفاده از آگار YEPD
- YEPD به عنوان یک محیط رشد برای رشد کشتهای مخمر استفاده میشود.
- برای رشد ساکارومایسس سرویزیه استفاده میشود.
- این محیط از رشد بیشتر میکروارگانیسمهای هتروتروف (Heterotrophic) پشتیبانی میکند، اما به دلیل ترکیب سادهشان، به عنوان محیط پایه برای کشت معمول مخمرها به کار گرفته میشوند.
- برای تهیه محیط کشت در روشهای میکروبیولوژی مولکولی استفاده میشود.
محدودیتهای آگار YEPD
- این محیط یک محیط غیر انتخابی است.
- از آنجایی که YEPD یک محیط کامل است، نمیتواند به عنوان یک محیط انتخابی برای آزمایش اکسوتروفها (Auxotroph) استفاده شود.
جهت خرید و یا استعلام قیمت با ما تماس بگیرید یا در واتسپ پیام بزارید
همچنین بخوانید:
- محیط کشت لوینتال (Levinthal’s Medium): ترکیب، اصول، روش آمادهسازی، نتایج و موارد استفاده
- پتری دیش چیست؟ تعریف، قطعات، انواع، موارد استفاده
- محیط کشت لون اشتاین جانسون (LJ): ترکیب، اصول، روش آمادهسازی، نتایج و موارد استفاده
- محیط کشت لوفلر (Loeffler Medium): ترکیب، اصول، روش آمادهسازی، نتایج و موارد استفاده
مترجم: صادق حسینیکیا




محیط کشت مخمر ساکارومایسیس سروزیه یا همان اسلنت به طور دقیق با مقدار میشه ارسال کنید
محیط اسلنت مناسب برای کشت مخمر Saccharomyces cerevisiae، محیط YPD آگار با فرمول زیر است:
پپتون: ۲۰ گرم
عصاره مخمر: ۱۰ گرم
دکستروز: ۲۰ گرم
آگار: ۱۵ تا ۲۰ گرم
آب مقطر: ۱۰۰۰ میلیلیتر
پس از حل کامل، محیط را اتوکلاو کرده و درون لولههای استریل بهصورت شیبدار (اسلنت) ریخته و تا زمان جامد شدن در حالت مایل قرار دهید.